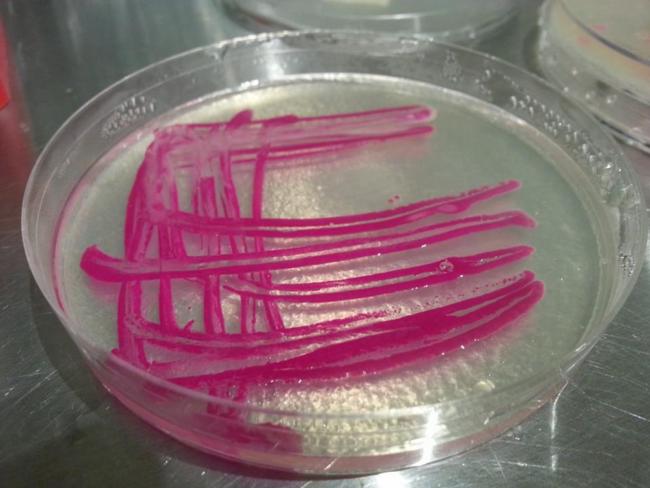

Please wait...
About This Project
BioLogik Labs
We need your help to open BioLogik to the public. We are building a functional lab located in Norfolk, Va suitable for amateur scientists and synthetic biologists alike. Help us launch today!
We believe in affordable access to scientific tools, citizen science, and science literacy. We are working to put science back into the hands of the individual through cheap workshops, low membership fees, training, and designing cost effective tools.
We believe in affordable access to scientific tools, citizen science, and science literacy. We are working to put science back into the hands of the individual through cheap workshops, low membership fees, training, and designing cost effective tools.
More Lab Notes From This Project

Browse Other Projects on Experiment
Related Projects
Zap-pore: DIY Electroporation for Global Biotech Accessibility and for plant genetic engineering
Zap-pore is a low-cost (10$), open-source DIY tool for electroporation, using everyday tools and common...
Exploring African biodiversity with an open-source educational program in Plant Synthetic Biology
Much of Africa's plants have not been studied. As a non-profit, SynBio4ALL aims to study plant biodiversity...
Empowering high school students in genome sequencing and bioinformatics
This project transforms HS science education by integrating real-time DNA barcoding and bioinformatics into...